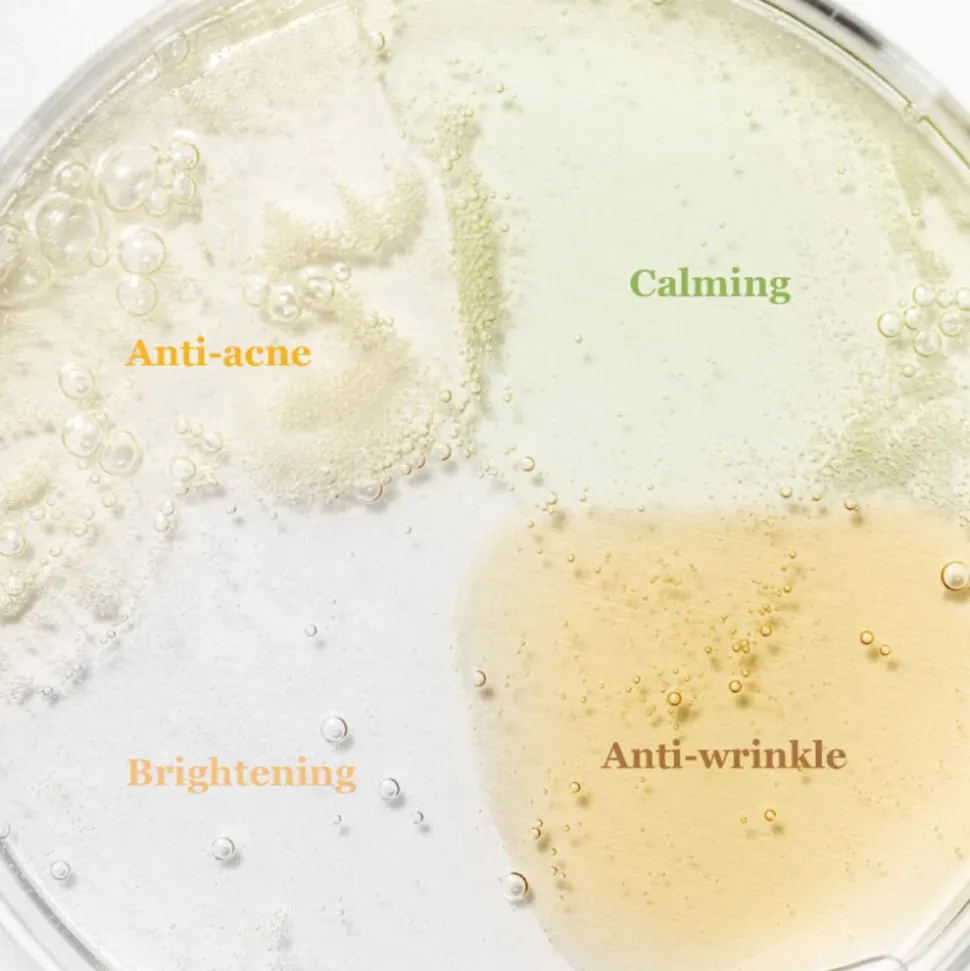
Beauty of Joseon Hanbang Serum Discovery Kit 40 ml

Beauty of Joseon Hanbang Serum Discovery Kit
Het Beauty of Joseon Hanbang Serum Discovery Kit biedt een verzameling van hoogwaardige, op hanbang gebaseerde serums die de huid voeden, hydrateren en herstellen. Elk serum in deze kit is geformuleerd met traditionele Koreaanse kruidenextracten om de huidtextuur te verbeteren en een gezonde teint te bevorderen.
- Hanbang Tradition: De serums in deze kit zijn geïnspireerd op de eeuwenoude hanbang traditie, waarbij natuurlijke kruiden worden gebruikt om de huid te verjongen en te revitaliseren.
- Hydratatie en voeding: Elk serum is samengesteld met voedende ingrediënten die diep doordringen in de huid om intensieve hydratatie te bieden en de huidbarrière te versterken.
- Verbeterde huidtextuur: Door regelmatig gebruik helpen de serums bij het verfijnen van de huidtextuur, het verminderen van fijne lijntjes en het bevorderen van een jeugdige uitstraling.
Gebruiksaanwijzing
Breng na het reinigen van de huid een kleine hoeveelheid serum aan op het gezicht en de hals. Masseer het serum zachtjes in met opwaartse bewegingen tot het volledig is opgenomen. Gebruik de serums ’s ochtends en ’s avonds als onderdeel van je dagelijkse huidverzorgingsroutine. Volg op met een geschikte moisturizer en zonbescherming tijdens de dagelijkse blootstelling aan de zon.
Raadpleeg de verpakking van elk individueel serum in de Discovery Kit voor de meest recente en specifieke ingrediëntenlijst.

Reviews
There are no reviews yet.